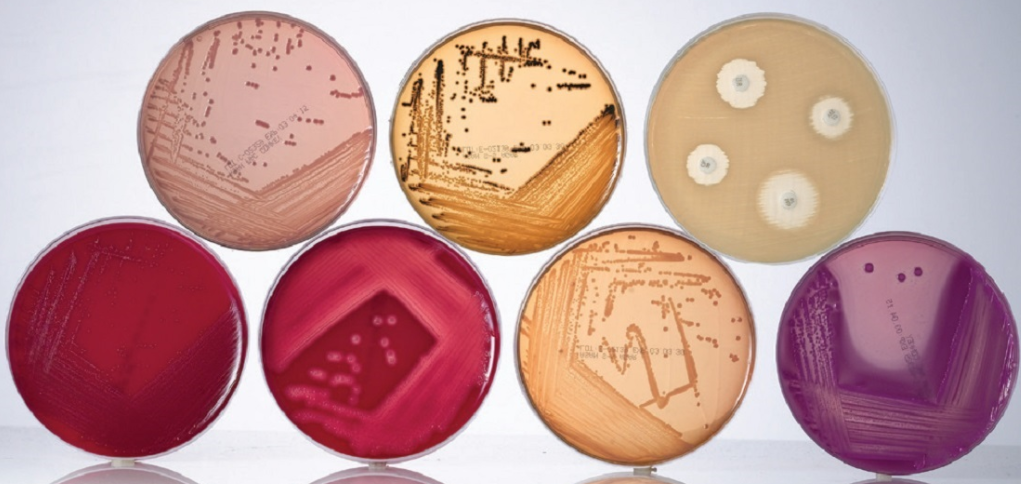

반응형
- 미생물 시험 시, 배지를 조제하여 사용하고 있습니까?
시험 목적과 필요에 따라 자체 조제 배지를 사용하거나, 인증된 외부 제조사의 배지를 구매하여 사용한다. 자체 조제 시 멸균과 균질성을 확보하기 위해 표준 절차에 따라 진행한다. - 구매 또는 조제한 배지 사용 시, 배지성능 평가를 진행하고 있습니까?
모든 배지는 사용 전 배지성능시험을 실시한다. 성장촉진능력(Growth Promotion Test), 선택억제능력, 배지무균성을 확인하여 합격한 경우에만 시험에 사용한다. - 과학적인 근거(예: 배지성능시험을 통한 확인 등)에 따라 미생물 배지 사용기간을 설정하였습니까?
배지 사용기간은 배지성능시험 결과와 문헌 자료를 근거로 설정하며, 설정된 기간은 라벨에 명시하여 관리한다. 필요 시 주기적인 재검증을 통해 기간을 조정한다. - 미생물 배지와 균주는 사용 후 문서화된 절차에 따라 교차오염과 잔류물을 방지할 수 있도록 폐기되고 있습니까?
사용 후 배지와 균주는 Autoclave 멸균 처리 후 폐기하며, 절차는 문서화되어 있다. 이를 통해 교차오염 및 잔류 위험을 차단한다. - 균주의 경우 1회 사용입니까? 또는 계대배양을 하고 있습니까? 계대배양 시, 몇 회를 최대로 하고 있습니까?
균주는 주로 1회 사용을 원칙으로 하며, 불가피하게 계대배양을 하는 경우 최대 5회 이내로 제한한다. 이 횟수는 내부 기준서에 명확히 규정되어 있다. - 미생물 시험결과에 대해서는 사진으로 찍어 시험기록지에 부착하고 있습니까?
시험 결과는 사진 촬영 후 시험기록지에 첨부하여 기록과 일치성을 보장한다. 사진은 검체 식별번호와 연계해 관리한다. - 미생물 시험실에서 사용되는 Autoclave는 적격성평가가 되었습니까?
Autoclave는 설치적격성(IQ), 운전적격성(OQ), 성능적격성(PQ)을 거쳐 사용 중이며, 정기적인 재평가도 실시한다. - Autoclave 적격성평가 시, Loading test는 완료되었습니까?
Loading test를 실시하여 실제 사용 조건에서 멸균이 균일하게 이루어짐을 확인하였다. 주기적으로 재검증을 수행한다. - Bio Safety Cabinet(BSC), clean bench, Isolator 중 무엇을 사용하고 있습니까?
시험 특성에 따라 BSC와 Clean Bench를 사용한다. 무균 시험에는 Isolator를 사용할 수 있도록 시설을 구비해두었다. - BSC 또는 Isolator에 대한 적격성 평가 및 Recovery Test에 대해 진행하였습니까?
BSC와 Isolator는 설치 후 적격성 평가를 완료하였으며, 주기적으로 Recovery Test를 통해 공기 청정도 회복 성능을 검증한다. - Isolator 등 glove가 체결된 장비인 경우 leak test를 주기적으로 실시하고 있습니까?
Isolator glove는 정기적으로 Leak test를 수행하여 완전성을 확인하고, 이상 발견 시 즉시 교체한다. - 미생물 Incubator에 대해 주기적으로 적격성평가 또는 교정을 실시하고 있습니까?
Incubator는 정기적으로 온도 정확성 및 균일성에 대한 적격성 평가를 실시하고, 필요 시 외부 교정을 통해 신뢰성을 보장한다. - 미생물 Incubator는 진균, 세균을 나누어 관리하고 있습니까?
진균 배양과 세균 배양은 별도의 Incubator를 사용하여 교차오염 가능성을 차단한다. - Incubator의 온도 이탈 시, 온도 이탈에 대한 알람 시스템이 있습니까?
Incubator에는 온도 모니터링 및 알람 시스템이 구축되어 있으며, 온도 이탈 발생 시 즉각적으로 경고가 발생한다. - 청정도가 높아지는 구역으로 물품 입고 시, 별도의 물동선이 있습니까? (예: Pass box 등)
청정 구역에는 Pass box를 통해 물품을 이송한다. 물품 이송 전·후에는 소독 절차를 거쳐 청정도 기준을 유지한다.

반응형

2025.06.03 - [COFFEEPHARM QCLAB ] - About Us
About Us
커피 한 잔에도 믿음이 필요하다고 느낀 적 있는가. 예쁜 카페, 감성적인 분위기, 고급 원두라는 말은 흔하다. 하지만 정말 이 커피가 어디서, 어떻게 만들어졌고, 내가 마신 이 맛이 다음에 와도
qclab.kr
반응형
'품질관리(Quality Control) > GMP FAQ' 카테고리의 다른 글
| 적외선 분광법(IR spectroscopy) 분석 시 스펙트럼의 베이스라인(baseline)이 왜곡되거나 휘어지는 원인? (0) | 2025.10.20 |
|---|---|
| GMP 제약회사 품질관리 "검체채취" 관련 실사 질문 및 답변 (2) | 2025.10.13 |
| GMP 품질관리 기기 관리 및 DI 관련 실사 질문 및 답변 (2) | 2025.10.09 |
| 제약회사 품질관리 GMP 표준품 및 시약 관리 관련 6개 질문 및 답변 (1) | 2025.10.08 |
| 제약회사 품질관리 GMP 질문 실사 "검체 관리"편 (0) | 2025.10.07 |